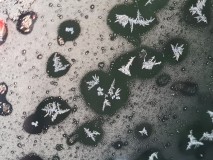
20221208_074956

Dex
Album Permissions
You can view images in this album
You cannot upload new images in this album
You cannot edit your images in this album
You cannot delete your images in this album
You cannot post comments to images in this album
You cannot rate images in this album